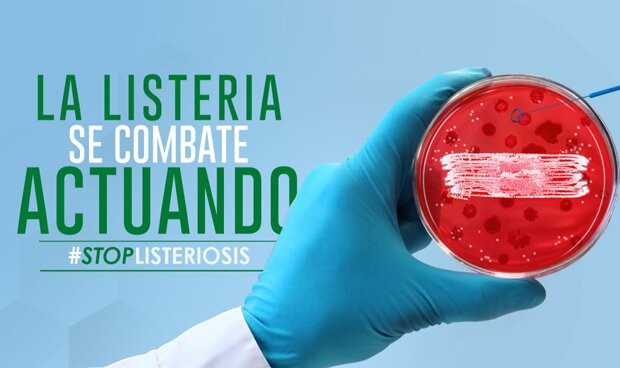

Imagen de la página web.
La consejería de
Salud y Familias de la Junta de Andalucía ha creado una
página web (
alertalisteriosis.es) que
recoge “toda la información” sobre el brote de listeriosis en la comunidad, según ha explicado el propio consejero,
Jesús Aguirre, a través de un mensaje en Twitter. En concreto, este portal contiene consejos, datos y la evolución del caso desde la primera alerta.
Bajo el lema
“La listeria se combate actuando #StopListeriosis”, que preside la portada de la página web, este espacio está consta de
cinco epígrafes. El primero de ellos informa sobre
qué es el microbio de la listeriosis, el siguiente del
grado de virulencia del brote -el segundo más importante del mundo y el primero de la Unión Europea con los datos que tenemos hasta la fecha- y el tercero de quiénes son las
personas con un perfil de riesgo: embarazadas, recién nacidos, mayores de 65 años y personas con el sistema inmunitario debilitado.
El cuarto apartado está destinado a los
síntomas, que dependen del perfil de la persona afectada-, los cuales son, según la web: dolor de cabeza, rigidez de cuello, confusión o disminución de la agudeza mental, pérdida del equilibrio y convulsiones.
Respecto al último capítulo, Salud señala una serie de
consejos para prevenir y evitar contraer la listeriosis. Principalmente, el departamento recomienda toma
r medidas higiénicas en la cocina, en especial con los alimentos crudos; cocinar a altas temperaturas y lavar frutas y verduras; lavarse las manos, utensilios y superficies de la cocina; y procurar que los alimentos crudos estén separados antes del consumo, sobre todo los mariscos, las carnes, el pescado y los vegetales.
Datos actualizados

Gráfico explicativo alojado en la página web.
|
Asimismo, la página web facilitada por la consejería detenta
datos actualizados sobre el caso. En concreto, y en la actualidad, la
tasa de supervivencia en el caso de Andalucía se sitúa en el 98.6 por ciento,
31.000 embarazadas se encuentran bajo control médico, la
red de hospitales públicos implicados es de 48, y hay un total de 25 centros privados involucrados.
A través de un mapa mundi, además, la web explica cuáles han sido los brotes de listeriosis que se han detectado a lo largo y ancho de todo el planeta. El primero de ellos se produjo en
Dinamarca entre 1997 y 2012 con 229 pacientes y un índice de mortalidad del 26.6 por ciento, mucho más elevado que en
Andalucía. En este país, un total de 61 personas perdieron la vida frente a las tres víctimas que, de momento, ha fallecido en la comunidad.
En total, en los últimos años, junto con el de Andalucía, en el mundo, ha habido seis grandes brotes. El citado en Dinamarca, en Francia -con la mayor tasa de mortalidad, 34 por ciento-, en
Estados Unidos, en
Sudáfrica, y otro en
España, que se produjo entre 1997 y 2015 y causó 960 fallecidos.
Por último, la Consejería de Sanidad incluye una
cronología de la alerta en la que explica todas las actuaciones que se han ido llevando a cabo para la gestión del brote. Además, incluye todas las notas de prensa que han publicado sobre este caso para que toda la información que se ha hecho pública este recogida en un mismo espacio.
Las informaciones publicadas en Redacción Médica contienen afirmaciones, datos y declaraciones procedentes de instituciones oficiales y profesionales sanitarios. No obstante, ante cualquier duda relacionada con su salud, consulte con su especialista sanitario correspondiente.